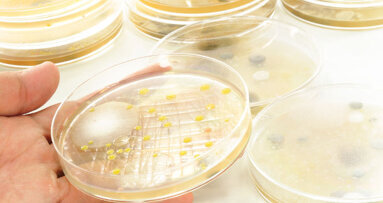
New research aims to stop biofilm from forming

LONDON, UK: Several studies have found that the oral health of care home residents is often poor and that in many cases carers have not received specific training to help residents with their daily oral hygiene routine. This problem is now being tackled in a new British health initiative that was recently launched by Health Education Kent, Surrey and Sussex, supported by research from the University of Greenwich’s Centre for Positive Ageing.
It is predicted that by 2020, around 20 per cent of the UK population will be aged 65 years or older. With increasing age, many people have to face a deterioration in physical and cognitive abilities and often need care.
The Improving Oral Health of Older Persons Initiative aims to improve oral health and quality of life for older people living in residential care homes in Kent, Surrey and Sussex through education and training of care home staff. “By helping to raise awareness of the importance of good oral health, both for quality of life and for general health, and by introducing oral health training for carers within this community, we aim to establish a sustainable quality standard for the oral healthcare of older persons,” the initiative stated.
In order to implement its measures, the initiative builds on research into the experiences of older patients and their carers by Dr Paul Newton, a research fellow at the Centre for Positive Ageing. Newton is an expert in patient empowerment and the management of chronic conditions. His work for the initiative has led to new training methods and information for carers of people living with dementia.
“Research about identifying and managing dental pain and oral health problems for people living with dementia was lacking—both in the literature and in previous initiatives,” Newton said. “We have worked closely with the Older Person’s Initiative to make sure the oral health needs of this vulnerable group are addressed.”
Problems with teeth, gums and dentures can significantly affect the overall well-being of an older person and his or her quality of life. There is a range of oral health challenges for elderly people, including loosening teeth, dry mouth and difficulty with eating and using a toothbrush. These in turn can lead to poor nutrition, low self-esteem, social isolation and the exacerbation of other conditions, such as diabetes and cardiovascular disease.
Health Education Kent, Surrey and Sussex is a local education and training board, authorised as a sub-committee of Health Education England. It was established in April 2013, when it took on the functions of the old Kent, Surrey and Sussex Deanery, and aims to ensure that health care providers across the region have suitable staff with the necessary skills.
The Centre for Positive Ageing, based in the university’s Faculty of Education and Health, brings together 12 research clusters from across the university. It aims to understand and develop solutions to the problems facing individuals, like chronic pain and dementia, as well as those confronting society, such as meeting the care needs of a growing older population.
DUBLIN, Ireland: An unregulated use of fortified high-sugar food supplements is causing untold damage to the oral health of thousands of nursing home ...
BIRMINGHAM, UK: New research being carried out in collaboration with the University of Birmingham will allow dental students to train on dental models that ...
LEEDS, England: Improving oral healthcare for patients who have completed treatment for head and neck cancer remains a persistent challenge in the UK. Many ...
LONDON, UK: Coinciding with World Oral Health Day, Swedish brand FOREO, makers of the world's first electric toothbrush made entirely from silicone, ...
EDINBURGH, UK: The gap in dental caries rates between children living in the least and most deprived areas of Scotland is growing, according to the National...
LONDON, UK: During pregnancy, women are at a higher risk for dental disease owing to hormonal changes. Moreover, it has been found that maternal oral health...
LONDON, UK: British dental researchers have published a consensus statement that aims to raise awareness of oral health issues in sport. Through a review of...
LIVERPOOL – Owing to the absence of a uniform testing standard within the NHS, researchers have analysed a new test developed to classify ...
NEWCASTLE UPON TYNE – Biofilms are increasingly recognised as an important issue in dental and health care, as they can cause dental plaque, sinusitis...
SUNDERLAND, UK: Poor oral health is a significant public health concern in the UK, costing NHS England a reported £3.4 billion annually. A new project ...
Live webinar
Tue. 23 June 2026
1:00 am UTC (London)
Live webinar
Tue. 23 June 2026
6:00 pm UTC (London)
Live webinar
Tue. 23 June 2026
8:00 pm UTC (London)
Live webinar
Wed. 24 June 2026
1:00 pm UTC (London)
Live webinar
Wed. 24 June 2026
4:00 pm UTC (London)
Live webinar
Wed. 24 June 2026
5:30 pm UTC (London)
Dr. med. dent. Britta Hahn
Live webinar
Thu. 25 June 2026
7:00 pm UTC (London)
Dr. Hatem Algraffee, Cat Edney



 Austria / Österreich
Austria / Österreich
 Bosnia and Herzegovina / Босна и Херцеговина
Bosnia and Herzegovina / Босна и Херцеговина
 Bulgaria / България
Bulgaria / България
 Croatia / Hrvatska
Croatia / Hrvatska
 Czech Republic & Slovakia / Česká republika & Slovensko
Czech Republic & Slovakia / Česká republika & Slovensko
 France / France
France / France
 Germany / Deutschland
Germany / Deutschland
 Greece / ΕΛΛΑΔΑ
Greece / ΕΛΛΑΔΑ
 Hungary / Hungary
Hungary / Hungary
 Italy / Italia
Italy / Italia
 Netherlands / Nederland
Netherlands / Nederland
 Nordic / Nordic
Nordic / Nordic
 Poland / Polska
Poland / Polska
 Portugal / Portugal
Portugal / Portugal
 Romania & Moldova / România & Moldova
Romania & Moldova / România & Moldova
 Slovenia / Slovenija
Slovenia / Slovenija
 Serbia & Montenegro / Србија и Црна Гора
Serbia & Montenegro / Србија и Црна Гора
 Spain / España
Spain / España
 Switzerland / Schweiz
Switzerland / Schweiz
 Turkey / Türkiye
Turkey / Türkiye
 UK & Ireland / UK & Ireland
UK & Ireland / UK & Ireland
 International / International
International / International
 Brazil / Brasil
Brazil / Brasil
 Canada / Canada
Canada / Canada
 Latin America / Latinoamérica
Latin America / Latinoamérica
 USA / USA
USA / USA
 China / 中国
China / 中国
 India / भारत गणराज्य
India / भारत गणराज्य
 Pakistan / Pākistān
Pakistan / Pākistān
 Vietnam / Việt Nam
Vietnam / Việt Nam
 ASEAN / ASEAN
ASEAN / ASEAN
 Israel / מְדִינַת יִשְׂרָאֵל
Israel / מְדִינַת יִשְׂרָאֵל
 Algeria, Morocco & Tunisia / الجزائر والمغرب وتونس
Algeria, Morocco & Tunisia / الجزائر والمغرب وتونس
 Middle East / Middle East
Middle East / Middle East

To post a reply please login or register